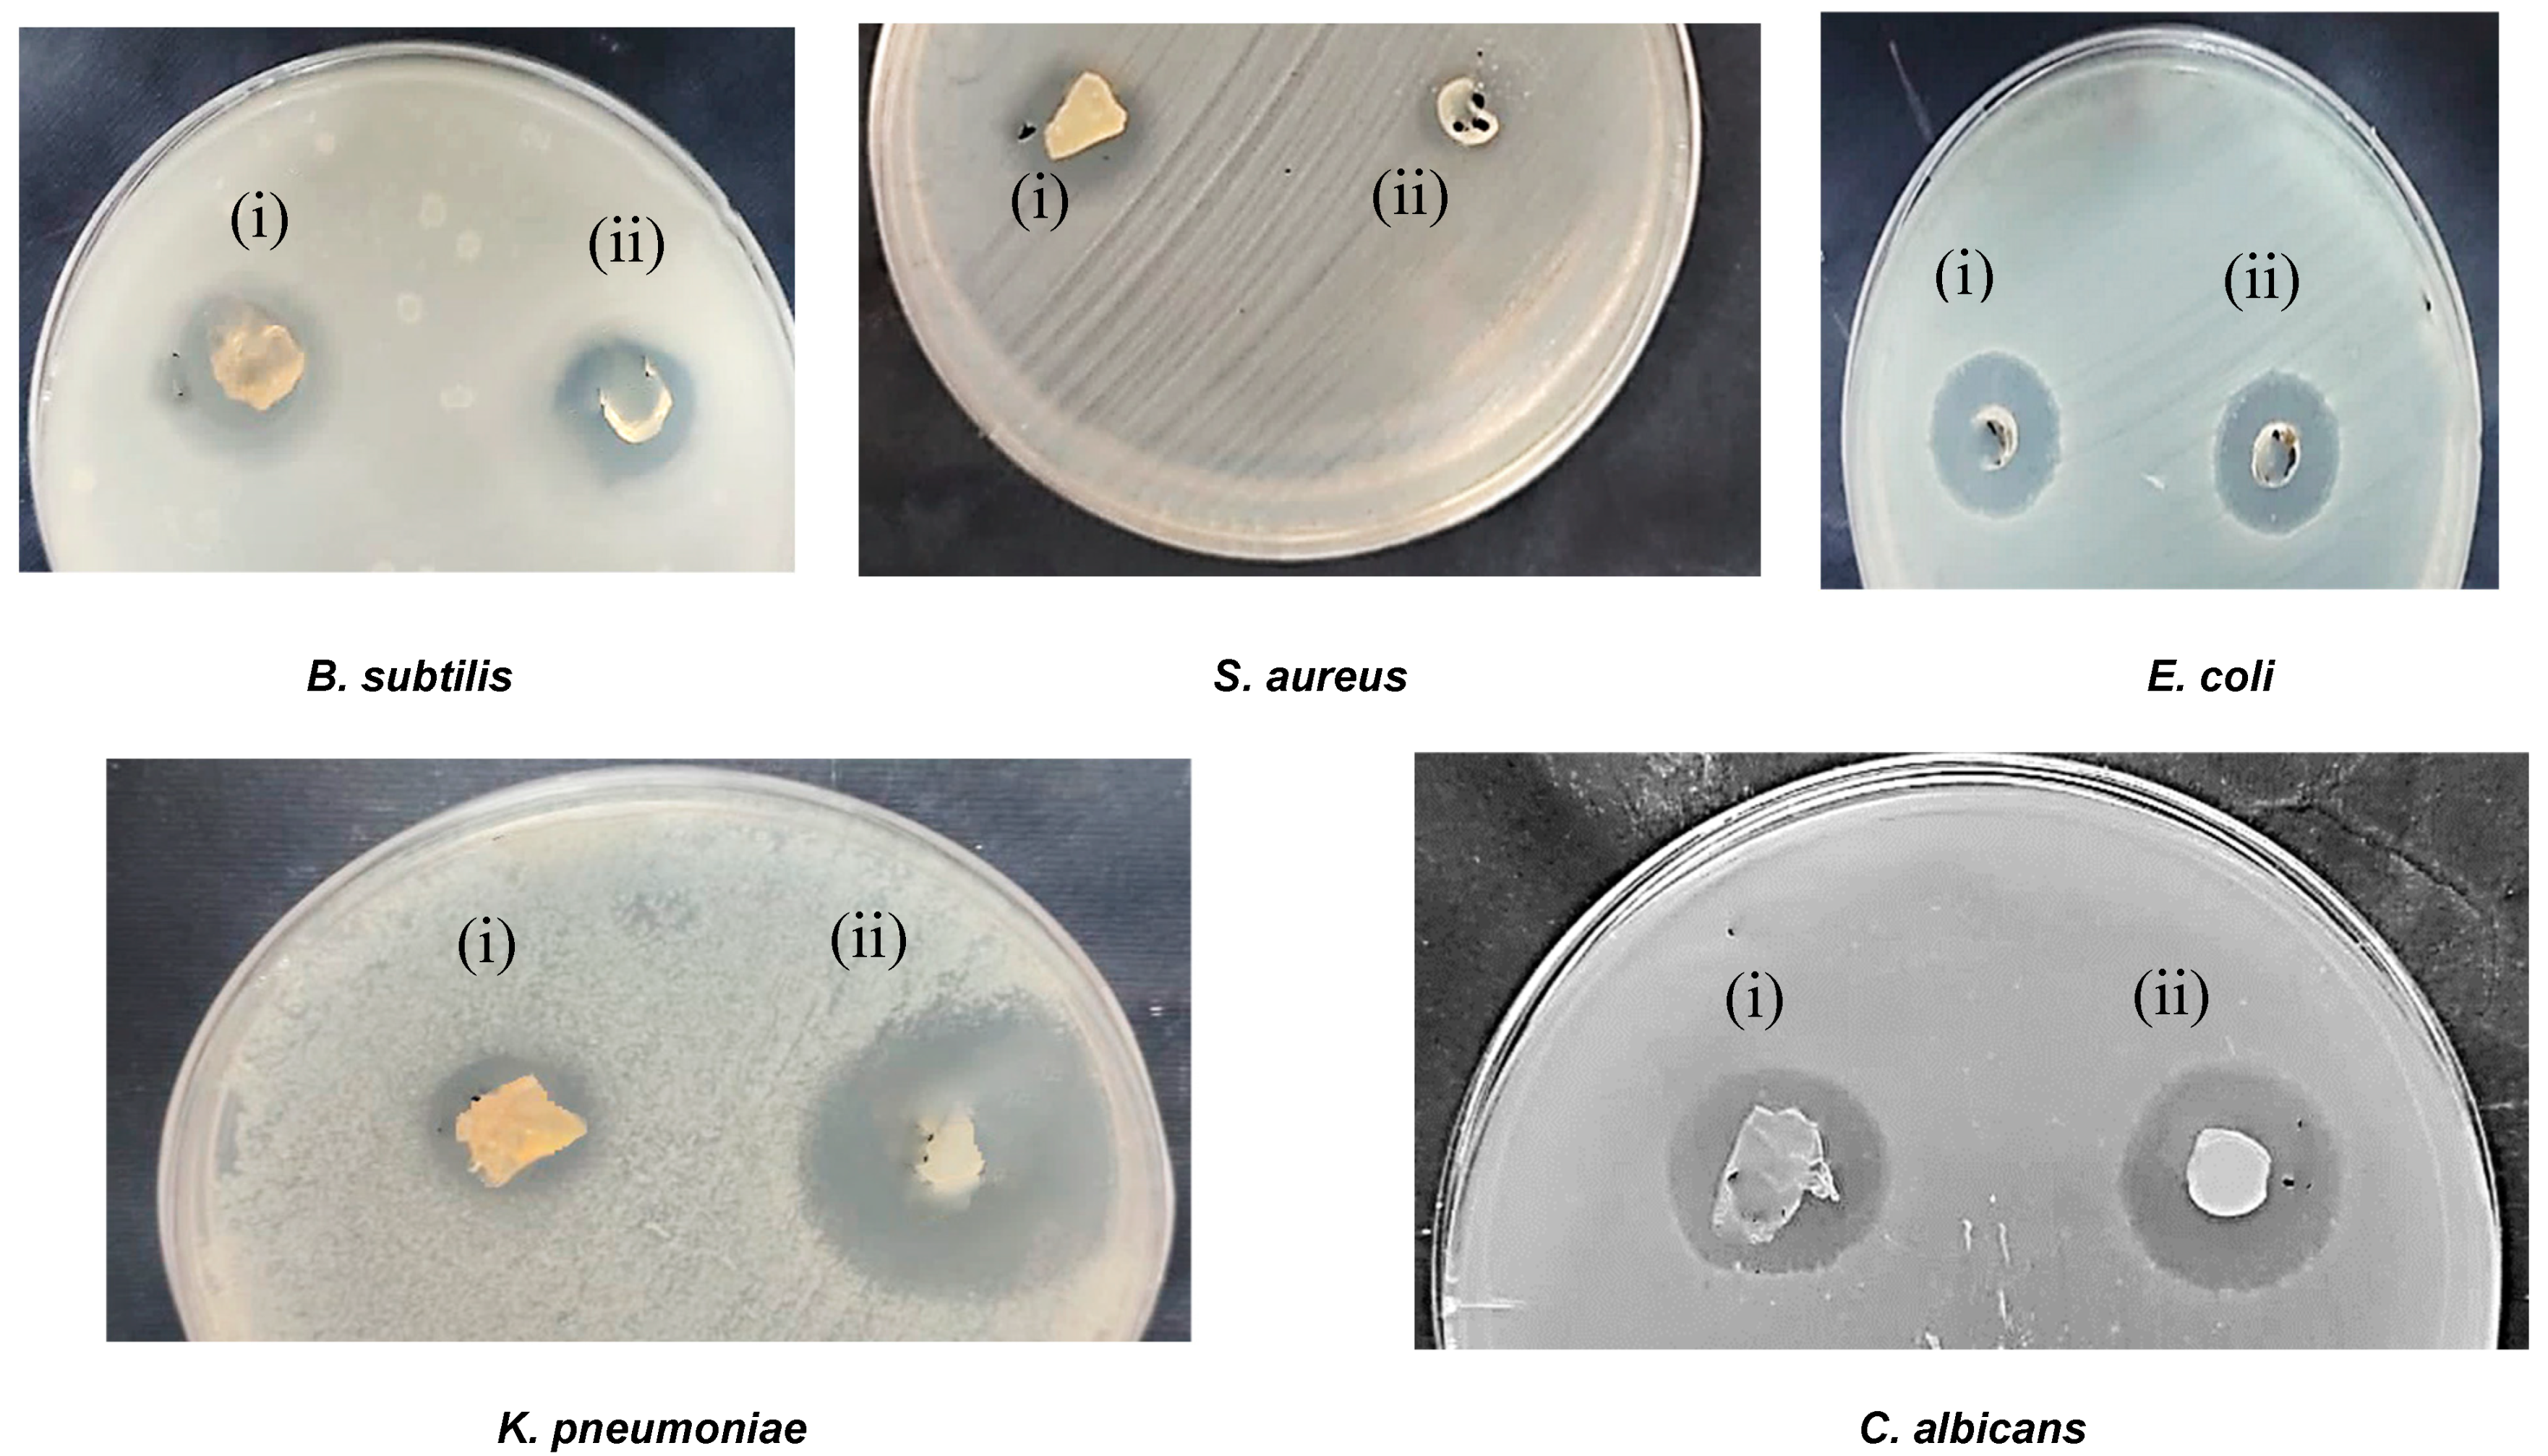
Processes 12 02702 g006b

New Carrageenan/2-Dimethyl Aminoethyl Methacrylate/Gelatin/ZnO Nanocomposite as a Localized Drug Delivery System with Synergistic Biomedical Applications
Abstract
:1. Introduction
2. Materials and Methods
2.1. Materials
2.2. Preparation of CAR/DEMA/Gelt/ZnO
2.3. Drug Loading to Hydrogel Nanocomposite
2.4. Fourier-Transform Infrared Spectroscopy (FT-IR)
2.5. X-Ray Powder Diffraction
2.6. Thermal Gravimetric Analysis (TGA)
2.7. Field Emission Scanning Electron Microscopy (FE-SEM)
2.8. Energy Dispersive X-Ray Spectroscopy (EDX)
2.9. Microbial Cultures and In Vitro Antimicrobial Assays
2.10. Anti-Inflammatory Assay
2.11. Antioxidant Assay
2.12. In Vitro Cytotoxicity on Cancer Cells
2.13. Statistical Analysis
3. Results and Discussion
3.1. Fourier-Transform Infrared (FTIR) Analysis
3.2. X-Ray Diffraction (XRD)
3.3. Thermal Stability of the Synthesized Hydrogel and the Nanocomposite
3.4. Surface Morphology and Structure of the Hydrogel and the Nanocomposite
3.5. Energy Dispersive X-Ray (EDX) Mapping Analysis
3.6. Antimicrobial Activity
3.7. Anti-Inflammatory Activity
3.8. Antioxidant Activity
3.9. In Vitro Cytotoxic Effect Against Cancer Cells
4. Conclusions
Author Contributions
Funding
Data Availability Statement
Conflicts of Interest
References
- Joshua, M.G.; Mansher, S.; David, J.M.; Elof, E.; Kristo, N. Antibiotic-Containing Agarose Hydrogel for Wound and Burn Care. J. Burn Care Res. 2019, 16, 900–906. [Google Scholar]
- Kirill, V.O.; Christian, K.; Tage, T.; Harald, C.; Dzung, B.D. Successful Development of Bacteriocins into Therapeutic Formulation for Treatment of MRSA Skin Infection in a Murine Model. Antimicrob. Agents Chemother. 2020, 64, e00829-20. [Google Scholar]
- Eid, M.; El-Arnaouty, M.; Salah, M.; Soliman, E.S.; Hegazy, E.-S.A. Radiation synthesis and characterization of poly (vinyl alcohol)/poly (N-vinyl-2-pyrrolidone) based hydrogels containing silver nanoparticles. J. Polym. Res. 2012, 19, 9835. [Google Scholar] [CrossRef]
- Sun, T.; Tao, H.; Xie, J.; Zhang, S.; Xu, X. Degradation and antioxidant activity of κ-carrageenans. J. Appl. Polym. Sci. 2010, 117, 194–199. [Google Scholar] [CrossRef]
- Cacciuttolo, M.A.; Trinh, L.; Lumpkin, J.A.; Rao, G. Hyperoxia induces DNA damage in mammalian cells. Free. Radic. Biol. Med. 1993, 14, 267–276. [Google Scholar] [CrossRef] [PubMed]
- Sun, T.; Zhou, D.; Xie, J.; Mao, F. Preparation of chitosan oligomers and their antioxidant activity. Eur. Food Res. Technol. 2007, 225, 451–456. [Google Scholar] [CrossRef]
- Choudhary, M.; bin Abdullah, A. Lipidomic Signatures in Oral Squamous Cell Carcinoma: Towards Personalized Treatment Strategies. J.Contemp. Healthc. Anal. 2023, 7, 145–162. [Google Scholar]
- Kashkooli, F.M.; Jakhmola, A.; Hornsby, T.K.; Tavakkoli, J.J.; Kolios, M.C. Ultrasound-mediated nano drug delivery for treating cancer: Fundamental physics to future directions. J. Control. Release 2023, 355, 552–578. [Google Scholar] [CrossRef] [PubMed]
- Sun, J.; Zhao, H.; Fu, L.; Cui, J.; Yang, Y. Global Trends and Research Progress of Photodynamic Therapy in Skin Cancer: A Bibliometric Analysis and Literature Review. Clin. Cosmet. Investig. Dermatol. 2023, 16, 479–498. [Google Scholar] [CrossRef]
- Verma, J.; Warsame, C.; Seenivasagam, R.K.; Katiyar, N.K.; Aleem, E.; Goel, S. Nanoparticle-mediated cancer cell therapy: Basic science to clinical applications. Cancer Metastasis Rev. 2023, 42, 601–627. [Google Scholar] [CrossRef]
- Hari, S.K.; Gauba, A.; Shrivastava, N.; Tripathi, R.M.; Jain, S.K.; Pandey, A.K. Polymeric micelles and cancer therapy: An ingenious multimodal tumor-targeted drug delivery system. Drug Deliv. Transl. Res. 2023, 13, 135–163. [Google Scholar] [CrossRef] [PubMed]
- Vangijzegem, T.; Lecomte, V.; Ternad, I.; Van Leuven, L.; Muller, R.N.; Stanicki, D.; Laurent, S. Superparamagnetic iron oxide nanoparticles (SPION): From fundamentals to state-of-the-art innovative applications for cancer therapy. Pharmaceutics 2023, 15, 236. [Google Scholar] [CrossRef] [PubMed]
- Marín, A.; Martín, M.; Liñán, O.; Alvarenga, F.; López, M.; Fernández, L.; Büchser, D.; Cerezo, L. Bystander effects and radiotherapy. Rep. Pract. Oncol. Radiother. 2015, 20, 12–21. [Google Scholar] [CrossRef] [PubMed]
- Nasiri, H.; Valedkarimi, Z.; Aghebati-Maleki, L.; Majidi, J. Antibody-drug conjugates: Promising and efficient tools for targeted cancer therapy. J. Cell. Physiol. 2018, 233, 6441–6457. [Google Scholar] [CrossRef] [PubMed]
- Wani, S.U.D.; Ali, M.; Masoodi, M.H.; Khan, N.A.; Zargar, M.I.; Hassan, R.; Mir, S.A.; Gautam, S.P.; Gangadharappa, H.V.; Osmani, R.A.M. A review on nanoparticles categorization, characterization and applications in drug delivery systems. Vib. Spectrosc. 2022, 121, 103407. [Google Scholar] [CrossRef]
- Chen, Y.; Qin, D.; Zou, J.; Li, X.; Guo, X.D.; Tang, Y.; Liu, C.; Chen, W.; Kong, N.; Zhang, C.Y.; et al. Living Leukocyte-Based Drug Delivery Systems. Adv. Mater. 2023, 35, 2207787. [Google Scholar] [CrossRef]
- Wang, H.; Zhou, Y.; Sun, Q.; Zhou, C.; Hu, S.; Lenahan, C.; Xu, W.; Deng, Y.; Li, G.; Tao, S. Update on nanoparticle-based drug delivery system for anti-inflammatory treatment. Front. Bioeng. Biotechnol. 2021, 9, 630352. [Google Scholar] [CrossRef]
- Ghoshal, G. Role of Nutraceutical-Based Functional Foods In Human Health. In Plant-Based Bioactive Compounds and Food Ingredients; Apple Academic Press: Palm Bay, FL, USA, 2024; pp. 113–142. [Google Scholar]
- Thakur, K.; Zhu, Y.Y.; Feng, J.Y.; Zhang, J.G.; Hu, F.; Prasad, C.; Wei, Z.J. Morin as an imminent functional food ingredient: An update on its enhanced efficacy in the treatment and prevention of metabolic syndromes. Food Funct. 2020, 11, 8424–8443. [Google Scholar] [CrossRef]
- Pang, Y.; Shi, R.; Chan, L.; Lu, Y.; Zhu, D.; Liu, T.; Yan, M.; Wang, Y.; Wang, W. The combination of the HDC1 inhibitor SAHA and doxorubicin has synergic efficacy in triple negative breast cancer in vivo. Pharmacol. Res. 2023, 196, 106926. [Google Scholar] [CrossRef]
- Li, S.; Li, F.; Wan, D.; Chen, Z.; Pan, J.; Liang, X.J. A micelle-based stage-by-stage impelled system for efficient doxorubicin delivery. Bioact. Mater. 2023, 25, 783–795. [Google Scholar] [CrossRef]
- Xiao, Y.; Gu, Y.; Qin, L.; Chen, L.; Chen, X.; Cui, W.; Li, F.; Xiang, N.; He, X. Injectable thermosensitive hydrogel-based drug delivery system for local cancer therapy. Colloids Surf. B 2021, 200, 111581. [Google Scholar] [CrossRef] [PubMed]
- Kesharwani, P.; Bisht, A.; Alexander, A.; Dave, V.; Sharma, S. Biomedical applications of hydrogels in drug delivery system: An update. J. Drug Deliv. Sci. Technol. 2021, 66, 102914. [Google Scholar] [CrossRef]
- Jahanban-Esfahlan, R.; Soleimani, K.; Derakhshankhah, H.; Haghshenas, B.; Rezaei, A.; Massoumi, B.; Farnudiyan-Habibi, A.; Samadian, H.; Jaymand, M. Multi-stimuli-responsive magnetic hydrogel based on Tragacanth gum as a de novo nanosystem for targeted chemo/hyperthermia treatment of cancer. J. Mater. Res. 2021, 36, 858–869. [Google Scholar] [CrossRef]
- Pacheco-Quito, E.M.; Ruiz-Caro, R.; Veiga, M.D. Carrageenan: Drug delivery systems and other biomedical applications. Mar. Drugs 2020, 18, 583. [Google Scholar] [CrossRef] [PubMed]
- Qureshi, D.; Nayak, S.K.; Maji, S.; Kim, D.; Banerjee, I.; Pal, K. Carrageenan: A wonder polymer from marine algae for potential drug delivery applications. Curr. Pharm. Des. 2019, 25, 1172–1186. [Google Scholar] [CrossRef]
- Zhang, S.; Qamar, S.A.; Junaid, M.; Munir, B.; Badar, Q.; Bilal, M. Algal Polysaccharides-Based Nanoparticles for Targeted Drug Delivery Applications. Starch 2022, 74, 2200014. [Google Scholar] [CrossRef]
- Mokhtari, H.; Tavakoli, S.; Safarpour, F.; Kharaziha, M.; Bakhsheshi-Rad, H.R.; Ramakrishna, S.; Berto, F. Recent advances in chemically-modified and hybrid carrageenan-based platforms for drug delivery, wound healing, and tissue engineering. Polymers 2021, 13, 1744. [Google Scholar] [CrossRef]
- Zhang, K.; Feng, Q.; Fang, Z.; Gu, L.; Bian, L. Structurally dynamic hydrogels for biomedical applications: Pursuing a fine balance between macroscopic stability and microscopic dynamics. Chem. Rev. 2021, 121, 11149–11193. [Google Scholar] [CrossRef]
- Mushtaq, F.; Raza, Z.A.; Batool, S.R.; Zahid, M.; Onder, O.C.; Rafique, A.; Nazeer, M.A. Preparation, properties, and applications of gelatin-based hydrogels (GHs) in the environmental, technological, and biomedical sectors. Int. J. Biol. Macromol. 2022, 218, 601–633. [Google Scholar] [CrossRef]
- Gunjan, B.; Sagar, R. ZnO Nanoparticles: A Promising Anticancer Agent. Nanobiomedicine 2016, 3, 9. [Google Scholar]
- Wang, Y.; Zhang, X.; Qiu, D.; Li, Y.; Yao, L.; Duan, J. Ultrasonic assisted microwave synthesis of poly (Chitosan-co-gelatin)/polyvinyl pyrrolidone IPN hydrogel. Ultrason. Sonochem. 2018, 40, 714–719. [Google Scholar] [CrossRef] [PubMed]
- El Sayed, M.M. Production of Polymer Hydrogel Composites and Their Applications. J. Polym. Environ. 2023, 31, 2855–2879. [Google Scholar] [CrossRef]
- Zhao, C.; Liu, G.; Tan, Q.; Gao, M.; Chen, G.; Huang, X.; Xu, X.; Li, L.; Wang, J.; Zhang, Y.; et al. Polysaccharide-based biopolymer hydrogels for heavy metal detection and adsorption. J. Adv. Res. 2023, 44, 53–70. [Google Scholar] [CrossRef] [PubMed]
- Bao, C.; Serrano-Lotina, A.; Niu, M.; Portela, R.; Li, Y.; Lim, K.H.; Liu, P.; Wang, W.J.; Bañares, M.A.; Wang, Q. Microwave-associated chemistry in environmental catalysis for air pollution remediation: A review. Chem. Eng. J. 2023, 466, 142902. [Google Scholar] [CrossRef]
- Basavarajappa, G.M.; Priyanka, K.M.; Goudanavar, P.; Narasimha, L.G.; Naveen, N.R.; Gowthami, B.; Fattepur, S.; Shiroorkar, P.N.; Nagaraja, S.; Telsang, M.; et al. A spotlight on application of microwave-assisted modifications of plant derived polymers in designing novel drug delivery systems. Des. Monomers Polym. 2023, 26, 106–116. [Google Scholar] [CrossRef]
- Ganguly, S.; Margel, S. Fluorescent quantum dots-based hydrogels: Synthesis, Fabrication and multimodal biosensing. Talanta Open 2023, 8, 100243. [Google Scholar] [CrossRef]
- Amini, E.; Valls, C.; Roncero, M.B. Ionic liquid-assisted bioconversion of lignocellulosic biomass for the development of value-added products. J. Clean. Prod. 2021, 326, 129275. [Google Scholar] [CrossRef]
- Soliman, E.A.; Khalil, A.A.; Deraz, S.F.; El-Fawal, G.; Abd Elrahman, S. Synthesis, characterization and antibacterial activity of biodegradable films prepared from Schiff bases of zein. J. Food Sci. Technol. 2014, 51, 2425–2434. [Google Scholar] [CrossRef]
- Fatimah, A.A.; Sahera, F.M. Synthesis and Characterization of a Self-Crosslinked Organic Copolymer Kappa-Carrageenan/Polyacrylamide/Cetrimide (κ-CAR/PAAm/CI) Hydrogel with Antimicrobial and Anti-Inflammatory Activities for Wound Healing. Chemistry 2023, 5, 2273–2287. [Google Scholar] [CrossRef]
- Zhou, J.; Sun, Y.Y.; Sun, M.Y.; Mao, W.A.; Wang, L.; Zhang, J.; Zhang, H. Prim-O-glucosylcimifugin Attenuates Lipopolysaccharide Induced Inflammatory Response in RAW 264.7 Macrophages. Pharmcogn. Mag. 2017, 13, 378–384. [Google Scholar]
- Fabian, I.E.; Philip, F.U.; Peter, I.; Bonaventure, C.O.; Patience, O.O. In vitro and In vivo Models for Anti-inflammation: An Evaluative Review. Theragnostic Pharmacol. Sci. 2019, 2, 3–15. [Google Scholar]
- Venkatesan, M.; Arumugam, V.; Pugalendi, R.; Ramachandran, K.; Sengodan, K.; Vijayan, S.R.; Sundaresan, U.; Ramachandran, S.; Pugazhendhi, A. Antioxidant, anticoagulant and mosquitocidal properties of water-soluble polysaccharides (WSPs) from Indian seaweeds. Process Biochem. 2019, 84, 196–204. [Google Scholar] [CrossRef]
- Santosh, K.B.Y.; Arun, M.I.; Mohan, K.G.C.; Inamuddin; Abdullah, M.A. Nanohydroxyapatite Reinforced chitosan composite Hydrogel with tunable Mechanical and Biological properties for cartilage Regeneration. Sci. Rep. 2019, 9, 15957. [Google Scholar]
- Phuong, L.T.; Yunki, L.; Thai, T.H.T.; Kyung, M.P.; Ki, D.P. Catechol-rich gelatin hydrogels in situ hybridizations with silver nanoparticle for enhanced antibacterial activity. Mater. Sci. Eng. C 2018, 92, 52–60. [Google Scholar]
- Maneesh, J.; Amit, K.D.; Asheesh, G.; Veena, K. Polycaprolactone diacrylate crosslinked biodegradable semi-interpenetrating networks of polyacrylamide and gelatin for controlled drug delivery. Biomed. Mater. 2010, 5, 065014. [Google Scholar]
- Zeferino, R.S.; Flores, M.B.; Pal, U. Photoluminescence and Raman scattering in Ag-doped ZnO nanoparticles. J. Appl. Phys. 2011, 109, 014308. [Google Scholar] [CrossRef]
- Nagaraju, G.; Prashanth, S.A.; Shastri, M.; Yathish, K.V.; Anupama, C.; Rangappa, D.J.M.R.B. Electrochemical heavy metal detection, photocatalytic, photoluminescence, biodiesel production and antibacterial activities of Ag–ZnO nanomaterial. Mater. Res. Bull. 2017, 94, 54–63. [Google Scholar] [CrossRef]
- Sun, N.; Lei, R.; Xu, J.; Kundu, S.C.; Cai, Y.; Yao, J.; Ni, Q. Fabricated porous silk fibroin particles for pH-responsive drug delivery and targeting of tumor cells. J. Mater. Sci. 2019, 54, 3319–3330. [Google Scholar] [CrossRef]
- Banerjee, S.S.; Chen, D.-H. Multifunctional pH-sensitive magnetic nanoparticles for simultaneous imaging, sensing and targeted intracellular anticancer drug delivery. Nanotechnology 2008, 19, 505104. [Google Scholar] [CrossRef]
- Ahmadi, A.; Ahmadi, P.; Sani, M.A.; Ehsani, A.; Ghanbarzadeh, B. Functional biocompatible nanocomposite films consisting of selenium and zinc oxide nanoparticles embedded in gelatin/cellulose nanofiber matrices. Int. J. Biol. Macromol. 2021, 175, 87–97. [Google Scholar] [CrossRef]
- Rasoulzadehzali, M.; Namazi, H. Facile preparation of antibacterial chitosan/graphene oxide-Ag bio-nanocomposite hydrogel beads for controlled release of doxorubicin. Int. J. Biol. Macromol. 2018, 116, 54–63. [Google Scholar] [CrossRef] [PubMed]
- Rana, S.; Gallo, A.; Srivastava, R.S.; Misra, R.D.K. On the suitability of nanocrystalline ferrites as a magnetic carrier for drug delivery: Functionalization, conjugation and drug release kinetics. Acta Biomater. 2007, 3, 233–242. [Google Scholar] [CrossRef] [PubMed]
- Abdulrahman, A.F.; Abd-Alghafour, N.M.; Ahmed, S.M. Optimization and characterization of SILAR synthesized ZnO nanorods for UV photodetector sensor. Sens. Actuator A Phys. 2021, 323, 112656. [Google Scholar] [CrossRef]
- Akgul, G.; Akgul, F.A. Impact of cobalt doping on structural and magnetic properties of zinc oxide nanocomposites synthesized by mechanical ball-milling method. Colloids Interface Sci. Commun. 2022, 48, 100611. [Google Scholar] [CrossRef]
- Lopez-Sanchez, P.; Martinez-Sanz, M.; Bonilla, M.R.; Wang, D.; Walsh, C.T.; Gilbert, E.P.; Stokes, J.R.; Gidley, M.J. Pectin impacts cellulose fibre architecture and hydrogel mechanics in the absence of calcium. Carbohydr. Polym. 2016, 153, 236–245. [Google Scholar] [CrossRef]
- Guan, Y.; Yu, C.; Zang, Z.; Wan, X.; Naeem, A.; Zhang, R.; Zhu, W. Chitosan/xanthan gum-based (Hydroxypropyl methylcellulose-co-2-Acrylamido-2-methylpropane sulfonic acid) interpenetrating hydrogels for controlled release of amorphous solid dispersion of bioactive constituents of Pueraria lobatae. Int. J. Biol. Macromol. 2023, 224, 380–395. [Google Scholar] [CrossRef]
- Joseph, B.; Mavelil Sam, R.; Balakrishnan, P.; Maria, H.J.; Gopi, S.; Volova, T.; Fernandes, S.C.M.; Thomas, S. Extraction of nanochitin from marine resources and fabrication of polymer nanocomposites: Recent advances. Polymers 2020, 12, 1664. [Google Scholar] [CrossRef] [PubMed]
- Jumaidin, R.; Sapuan, S.M.; Jawaid, M.; Ishak, M.R.; Sahari, J. Seaweeds as renewable sources for biopolymers and its composites: A review. Curr. Anal. Chem. 2018, 14, 249–267. [Google Scholar] [CrossRef]
- Dave, P.N.; Macwan, P.M.; Kamaliya, B. Drug release and thermal properties of magnetic cobalt ferrite (CoFe2O4) nanocomposite hydrogels based on poly (acrylic acid-gN-isopropyl acrylamide) grafted onto gum ghatti. Int. J. Biol. Macromol. 2023, 224, 358–369. [Google Scholar] [CrossRef]
- Torğut, G.; Yazdıç, F.C.; Gürler, N. Synthesis, characterization, pH-sensitive swelling and antimicrobial activities of chitosan–graft-poly (hydroxyethyl methacrylate) hydrogel composites for biomedical applications. Polym. Eng. Sci. 2022, 62, 2552–2559. [Google Scholar] [CrossRef]
- Mota, H.P.; Fajardo, A.R. Development of superabsorbent hydrogel based on Gum Arabic for enhanced removal of anxiolytic drug from water. J. Environ. Manage. 2021, 288, 112455. [Google Scholar] [CrossRef] [PubMed]
- Oun, A.A.; Rhim, J.-W. Carrageenan-based hydrogels and films: Effect of ZnO and CuO nanoparticles on the physical, mechanical, and antimicrobial properties. Food Hydrocoll. 2017, 67, 45–53. [Google Scholar] [CrossRef]
- Jayaraman, P.; Gandhimathi, C.; Venugopal, J.R.; Becker, D.L.; Ramakrishna, S.; Srinivasan, D.K. Controlled release of drugs in electrosprayed nanoparticles for bone tissue engineering. Adv. Drug Deliv. Rev. 2015, 94, 77–95. [Google Scholar] [CrossRef] [PubMed]
- Arakelova, E.R.; Grigoryan, S.G.; Arsenyan, F.G.; Babayan, N.S.; Grigoryan, R.M.; Sarkisyan, N.K. In vitro and in vivo anticancer activity of nanosize zinc oxide composites of doxorubicin. Int. J. Med. Pharma. Sci. Eng. 2014, 8, 38–43. [Google Scholar]
- Arakelova, E.R.; Farmazyan, Z.M.; Khachatryan, A.M.; Avjyan, K.E.; Babayan, N.S.; Grigoryan, R.M.; Sarkisyan, N.K. In vitro study of anticancer activity of polymer-based DOX-ZnO compositions: The case of vinyl alcohol (co) polymers. J. Nanogen. Nanomed. 2014, 2, 1–11. [Google Scholar]
- Gleason, K.K. Designing Organic and Hybrid Surfaces and Devices with Initiated Chemical Vapor Deposition (iCVD). Adv. Mater. 2024, 36, 2306665. [Google Scholar] [CrossRef]
- Javed, H.M.A.; Qureshi, A.A.; Mustafa, M.S.; Que, W.; Mahr, M.S.; Shaheen, A.; Iqbal, J.; Saleem, S.; Jamshaid, M.; Mahmood, A. Advanced Ag/rGO/TiO2 ternary nanocomposite based photoanode approaches to highly-efficient plasmonic dye-sensitized solar cells. Opt. Commun. 2019, 453, 124408. [Google Scholar] [CrossRef]
- Tian, N.; Giannakis, S.; Akbarzadeh, L.; Hasanvandian, F.; Dehghanifard, E.; Kakavandi, B. Improved catalytic performance of ZnO via coupling with CoFe2O4 and carbon nanotubes: A new, photocatalysis-mediated peroxymonosulfate activation system, applied towards Cefixime degradation. J. Environ. Manage. 2023, 329, 117022. [Google Scholar] [CrossRef]
- Wang, F.F.; Yao, Z.; Wu, H.G.; Zhang, S.X.; Zhu, N.N.; Gai, X. Antibacterial activities of kappa-carrageenan oligosaccharides. Appl. Mech. Mater. 2012, 108, 194–199. [Google Scholar] [CrossRef]
- Aqsa, Z.; Muhammad, K.K.; Awal, N.; Sadaf, Q.; Muhammad, J.S. Carboxymethyl Cellulose/Gelatin Hydrogel Films Loaded with Zinc Oxide Nanoparticles for Sustainable Food Packaging Applications. Polymers 2022, 14, 5201. [Google Scholar] [CrossRef]
- Agarwal, H.; Menon, S.; Kumar, S.V.; Rajeshkumar, S. Mechanistic study of the antibacterial action of zinc oxide nanoparticles synthesized using green route. Chem.-Biol. Inter. 2018, 286, 60–70. [Google Scholar] [CrossRef]
- Burman, U.; Saini, M.; Kumar, P. Effect of zinc oxide nanoparticles on growth and antioxidant system of chickpea seedlings. Toxicol. Environ. Chem. 2013, 95, 605–612. [Google Scholar] [CrossRef]
- Siddiqi, K.S.; Rahman, A.; Husen, A. Properties of zinc oxide nanoparticles and their activity against microbes. Nanoscale Res. Lett. 2018, 13, 141. [Google Scholar] [CrossRef]
- Moohan, J.; Stewart, S.A.; Espinosa, E.; Rosal, A.; Rodríguez, A.; Larrañeta, E.; Donnelly, R.F.; Domínguez-Robles, J. Cellulose nanofibers and other biopolymers for biomedical applications. A review. Appl. Sci. 2019, 10, 65. [Google Scholar] [CrossRef]
- Azadikhah, F.; Karimi, A.R.; Yousefi, G.H.; Hadizadeh, M. Dual antioxidant-photosensitizing hydrogel system: Cross-linking of chitosan with tannic acid for enhanced photodynamic efficacy. Int. J. Biol. Macromol. 2021, 188, 114–125. [Google Scholar] [CrossRef]
- Li, K.; Zhong, W.; Li, P.; Ren, J.; Jiang, K.; Wu, W. Recent advances in lignin antioxidant: Antioxidant mechanism, evaluation methods, influence factors and various applications. Int. J. Biol. Macromol. 2023, 251, 125992. [Google Scholar] [CrossRef]
- Yasmeen, F.; Karamat, H.; Rehman, R.; Akram, M.; Ghfar, A.A.; Abdelghani, H.T.M.; Dar, A.; Mitu, L. Fabrication and testing of edible films incorporated with ZnO nanoparticles to enhance the shelf life of bread. Food Biosci. 2023, 56, 103111. [Google Scholar] [CrossRef]
- Mohd Zabidi, A.R.; Lim, W.F. Formation of cerium oxide film via post-sputter oxidation of cerium in nitrogen/oxygen/nitrogen ambient. J. Alloys Compd. 2021, 851, 156786. [Google Scholar] [CrossRef]
- Turney, T.W.; Duriska, M.B.; Jayaratne, V.; Elbaz, A.; O’Keefe, S.J.; Hastings, A.S.; Piva, T.J.; Wright, P.F.A.; Feltis, B.N. Formation of zinc containing nanoparticles from Zn2+ ions in cell culture media: Implications for the nanotoxicology of ZnO. Chem. Res. Toxicol. 2012, 25, 2057–2066. [Google Scholar] [CrossRef] [PubMed]
- Rasmussen, J.W.; Martinez, E.; Louka, P.; Wingett, D.G. Zinc oxide nanoparticles for selective destruction of tumor cells and potential for drug delivery applications. Expert Opin. Drug Deliv. 2010, 7, 1063–1077. [Google Scholar] [CrossRef]
- Driscoll, K.; Howard, B.; Carter, J.; Janssen, Y.W.; Mossman, B.; Isfort, R. Mitochondrial-Derived Oxidants and Quartz Activation of Chemokine Gene Expression. In Biological Reactive Intermediates VI; Dansette, P., Snyder, R., Dela-Forge, M., Gibson, G.G., Greim, H., Jollow, D., Monks, T., Sipes, I., Eds.; Advances in Experimental Medicine and Biology; Springer: New York, NY, USA, 2001; Volume 500, pp. 489–496. [Google Scholar]
- Wilson, M.R.; Lightbody, J.H.; Donaldson, K.; Sales, J.; Stone, V. Interactions between Ultrafine Particles and Transition Metals in Vivo and in Vitro. Toxi-Cology Appl. Pharmacol. 2002, 184, 172–179. [Google Scholar] [CrossRef] [PubMed]
- Alemi, F.; Masomeh, M.; Mostafa, M.; Abbas, E.K.; Mojtaba, Z.; Bahman, Y.; Nadereh, R. Synthesis, characterization, and evaluation of pH-sensitive doxorubicin-loaded functionalized graphene oxide in osteosarcoma cells. BioImpacts 2023, 13, 207–218. [Google Scholar] [CrossRef]
- Varela-López, A.; Battino, M.; Navarro-Hortal, M.D.; Giampieri, F.; Forbes-Hernández, T.Y.; Romero-Márquez, J.M.; Ricardo, C.; José, L.Q. An update on the mechanisms related to cell death and toxicity of doxorubicin and the protective role of nutrients. Food Chem. Toxicol. 2019, 134, 110834. [Google Scholar] [CrossRef]

Disclaimer/Publisher’s Note: The statements, opinions and data contained in all publications are solely those of the individual author(s) and contributor(s) and not of MDPI and/or the editor(s). MDPI and/or the editor(s) disclaim responsibility for any injury to people or property resulting from any ideas, methods, instructions or products referred to in the content. |
© 2024 by the authors. Licensee MDPI, Basel, Switzerland. This article is an open access article distributed under the terms and conditions of the Creative Commons Attribution (CC BY) license (https://creativecommons.org/licenses/by/4.0/).
Share and Cite
Ageeli, A.A.; Mohamed, S.F. New Carrageenan/2-Dimethyl Aminoethyl Methacrylate/Gelatin/ZnO Nanocomposite as a Localized Drug Delivery System with Synergistic Biomedical Applications. Processes 2024, 12, 2702. https://doi.org/10.3390/pr12122702
Ageeli AA, Mohamed SF. New Carrageenan/2-Dimethyl Aminoethyl Methacrylate/Gelatin/ZnO Nanocomposite as a Localized Drug Delivery System with Synergistic Biomedical Applications. Processes. 2024; 12(12):2702. https://doi.org/10.3390/pr12122702
Chicago/Turabian StyleAgeeli, Abeer A., and Sahera F. Mohamed. 2024. "New Carrageenan/2-Dimethyl Aminoethyl Methacrylate/Gelatin/ZnO Nanocomposite as a Localized Drug Delivery System with Synergistic Biomedical Applications" Processes 12, no. 12: 2702. https://doi.org/10.3390/pr12122702
APA StyleAgeeli, A. A., & Mohamed, S. F. (2024). New Carrageenan/2-Dimethyl Aminoethyl Methacrylate/Gelatin/ZnO Nanocomposite as a Localized Drug Delivery System with Synergistic Biomedical Applications. Processes, 12(12), 2702. https://doi.org/10.3390/pr12122702




